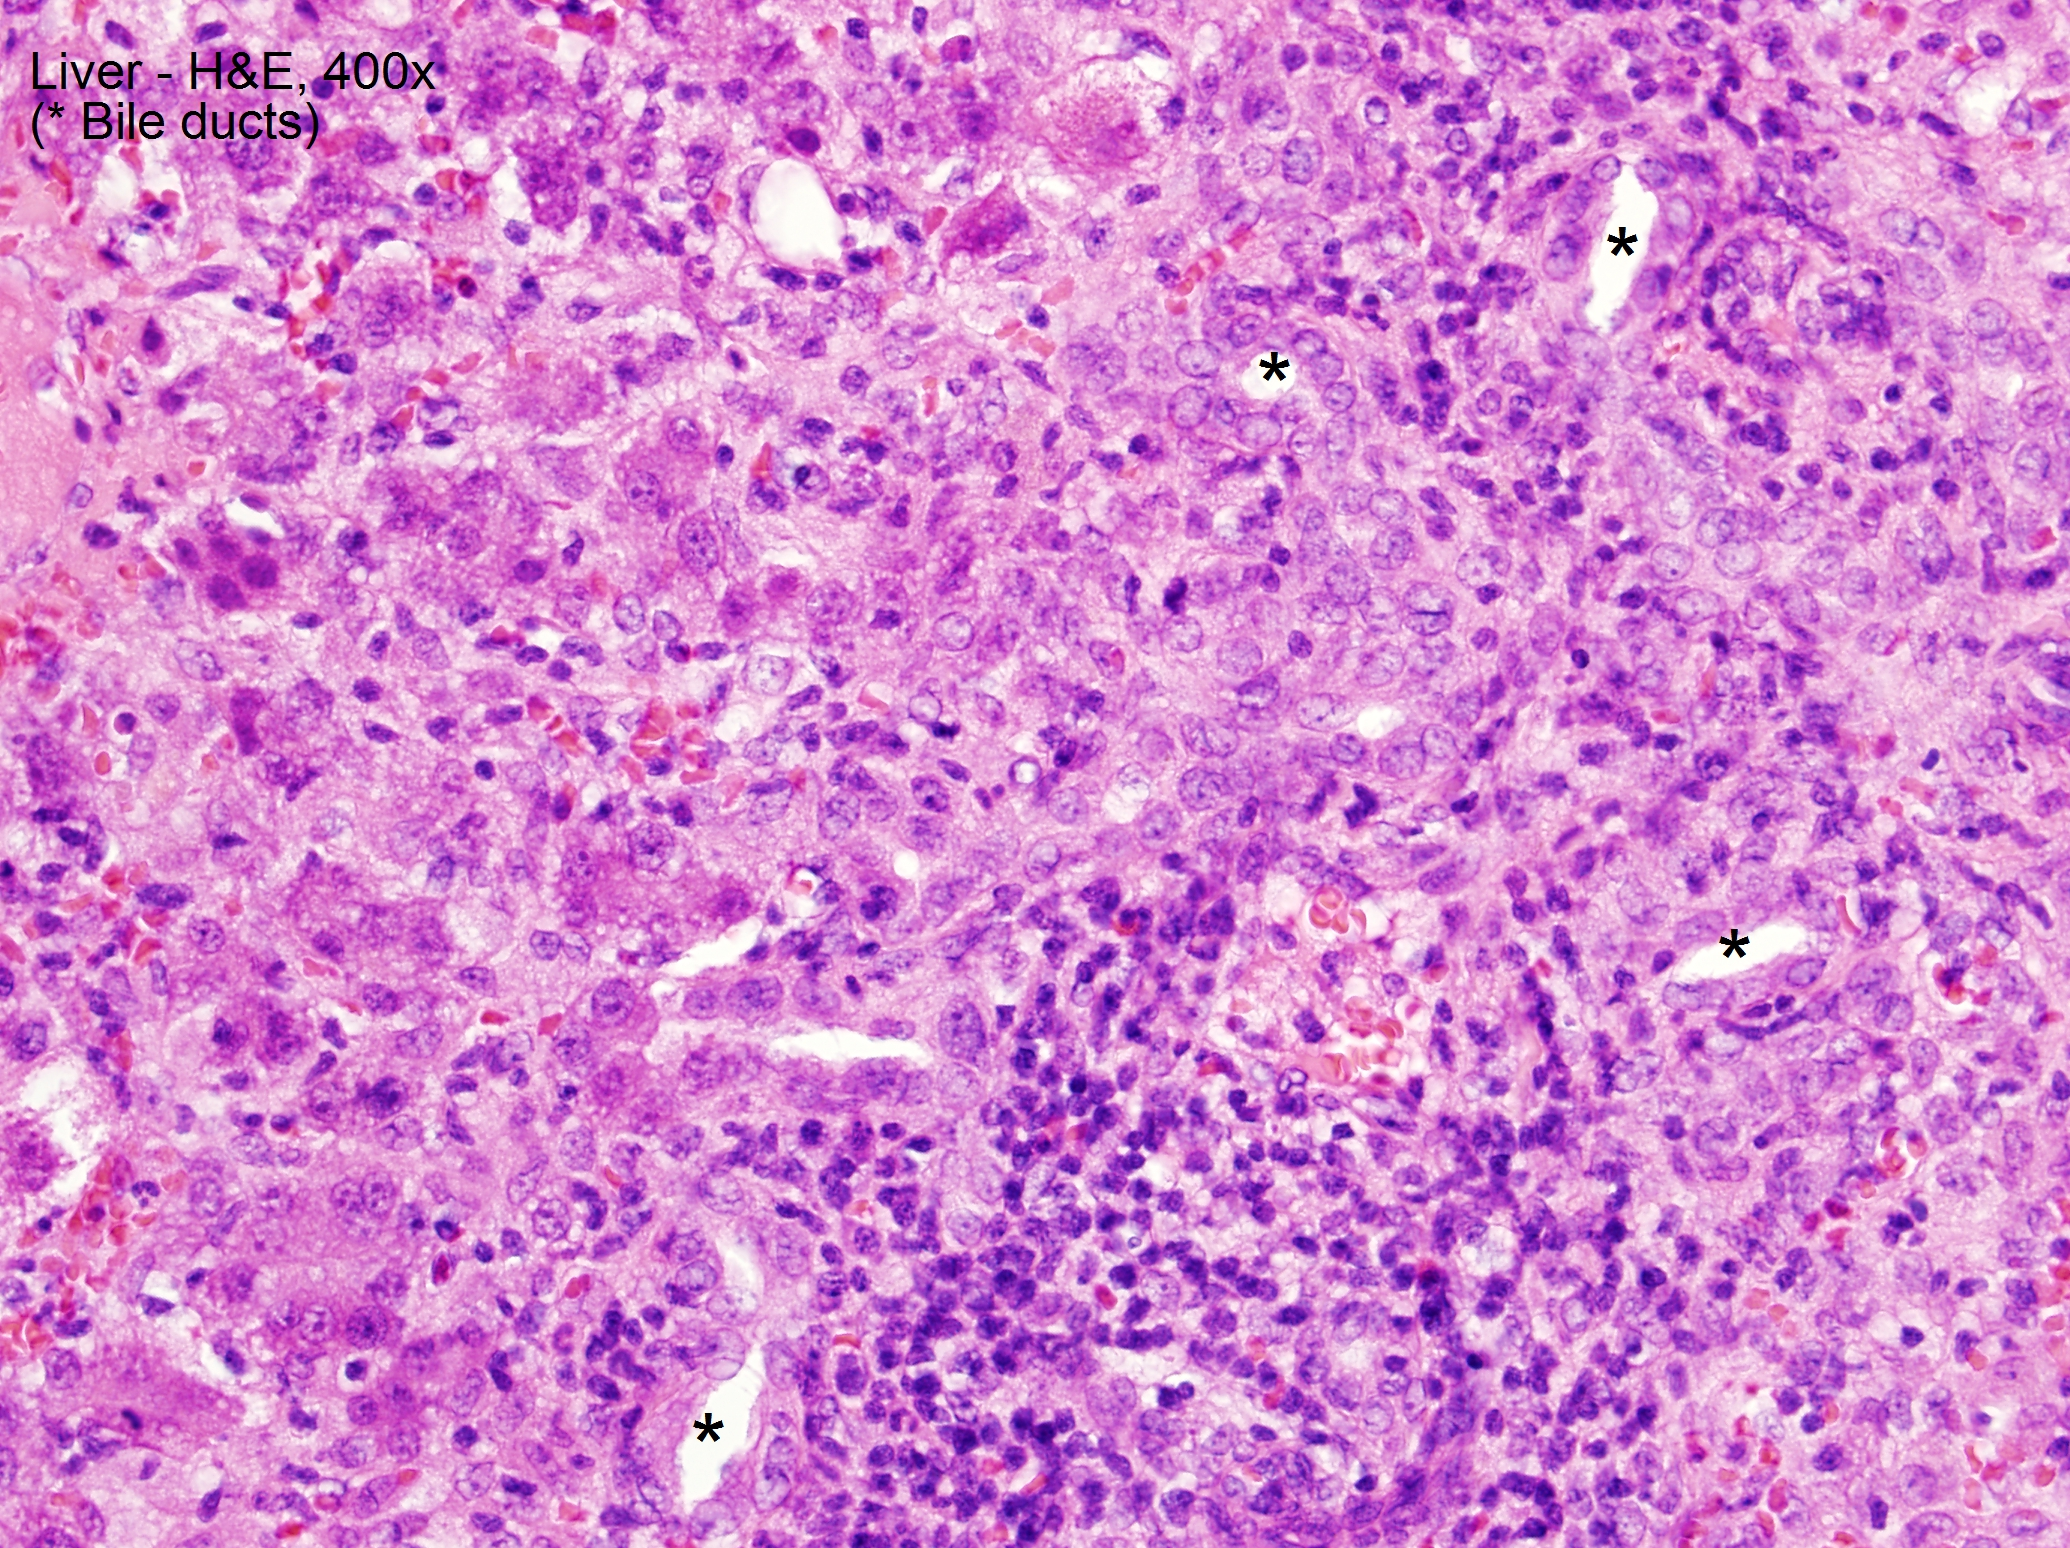

Case Presentation: We report a case of suspected sevoflurane hepatotoxicity in a 13-month-old male with repeated sevoflurane exposure. Prior to presentation, he was given sevoflurane as an inhaled anesthetic for 3 separate procedures related to Gtube removal and subsequent fistula and abscess formation. On presentation, he was found to be jaundiced and had scleral icterus. Labs revealed markedly elevated alkaline phosphatase (508), AST (1,500), ALT (1,869), total and direct bilirubin (5.3/3.8), PTT (40.2), and PT/INR (16.9/1.5). On day 3 of hospitalization, he underwent I&D under anesthesia and was exposed to sevoflurane again. After, he had a sharp increase in AST to peak >3,500. Multiple infectious disease titers and antibodies, tuberculin detection by T spot, and autoimmune work-up, including anti-smooth muscle antibody and anti-liver- kidney antibody, resulted as negative. Alpha -1 antitrypsin was within normal limits. Thyroid studies revealed a normal T4 (0.82) and slightly low TSH (0.28). Acetaminophen level on admission was <3. Liver biopsy demonstrated non-specific lobular and portal injury, characterized by giant-cell lobular changes and severe interface portal inflammation without necrosis or excessive copper or iron deposition. Our patient improved with conservative management.
Discussion: Sevoflurane is an inhaled anesthetic frequently used in the pediatric population that is a rare but documented cause of hepatotoxicity and even hepatonecrosis in adult patients. The exact mechanism of injury for sevoflurane hepatotoxicity is unknown. Some propose that it is due to production of reactive intermediates that bind proteins and create compounds that cause an immune reaction, and others propose that IGF-1 down regulation allows for hepatocyte necrosis and apoptosis. Genetics plays a role in a patient’s ability to metabolize drugs and toxins. Sevoflurane is proposed to be metabolized by the cytochrome P450 pathway in the liver. It is conceivable that some people have a genetic predisposition to the build up of reactive intermediates due to decreased amounts of the enzyme required to break down reactive intermediates to harmless metabolites.
Conclusions: Sevoflurane is a commonly used inhaled anesthetic in the pediatric population because of its timing of onset and safety profile. Hepatotoxicity secondary to sevoflurane is considered a diagnosis of exclusion, as there are no available confirmatory diagnostic tests. The differential diagnosis includes infection, autoimmune disease, metabolic disorder, and other toxins/exposures. It may be beneficial to avoid repeat exposure in children undergoing multiple procedures in a short span of time. There may be a role for pharmacogenetic testing in populations at high risk for requiring repeat exposure to general anesthesia to tailor a drug regimen that best suits the metabolic capabilities of the patient.